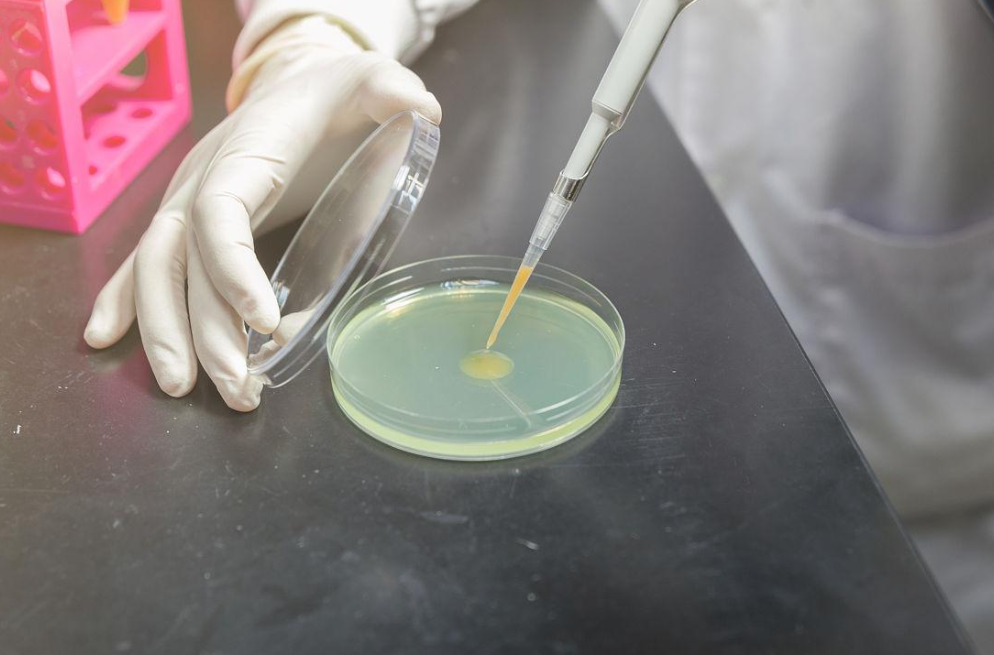
精液检查

在线咨询
逆行射精有必要做美国试管婴儿吗?
对于自然生育而言,逆行射精几乎是一道不可逾越的障碍。毕竟,精液不是向前经尿道射出,而是逆向流入膀胱。这在确诊后,许多夫妇将目光投向了辅助生殖技术,而其中,美国试管婴儿常常被视为终极解决方案。

美国HRC-Fertility生殖医疗中心专家表示,美国试管婴儿在应对逆行射精这一病症上,技术优势显著。
美国拥有先进的ICSI单精子注射技术,该技术可以直接将单一精子注入卵细胞中,实现受精过程。这对于逆行射精患者来说尤为重要,因为即使精液逆行进入膀胱,HRC专家也能通过特殊手段获取精子,并利用ICSI技术使其与卵子结合,大大提高受精的成功率。
美国试管婴儿应对逆行射精的具体方案:
1、前期准备
男性除了要进行精液常规检查,查看精子的数量、活性、形状等指标外,由于逆行射精的特殊性,还需着重检查生殖系统,排查是否存在其他影响生育的疾病,如附睾炎、前列腺炎等。同时,进行染色体分析也是很有必要的,以排除遗传性疾病对生育的影响。
2、取精策略
针对逆行射精患者,美国HRC常用的取精方法有膀胱尿液精子回收和手术取精。

膀胱尿液精子回收是较为常用的一种方法,适用于逆行射精程度较轻的患者。男性通过手淫达到性高潮后,立即排尿,收集尿液样本。在实验室中,胚胎学家会使用特殊的培养液多次洗涤尿液中的精子,去除尿液的有害成分(如酸性环境、代谢废物),并浓缩、优化精子,为后续的试管婴儿环节做准备。

当膀胱尿液精子回收无法获取足够数量或质量的精子时,手术取精则成为另一种有效的选择。手术取精包括经皮附睾穿刺取精(PESA)和睾丸穿刺取精(TESA)等。经皮附睾穿刺取精适用于附睾功能保留的逆行射精患者,HRC专家在超声引导下,将细针从皮肤刺入附睾部位,抽取附睾液,从中获得精子。整个操作过程在局部麻醉下完成,创伤较小,男性会恢复较快。睾丸穿刺取精则常用于附睾或射精功能障碍、无精症患者,HRC专家会用细针刺入睾丸组织,抽取少量组织及液体,经过离心分离获取其中的精子。
3、体外受精与胚胎培养

在获取精子和卵子后,就进入体外受精阶段。HRC专家通常会采用ICSI单精子注射技术,即直接将挑选出的优质精子注入卵细胞中,实现受精过程。这种方法能够有效解决因逆行射精导致的精子质量不佳或数量不足等问题,大大提高受精的成功率。
受精成功后,受精卵就会被放置在胚胎实验室中进行培养。胚胎实验室会模拟人体子宫的环境,为胚胎的发育提供适宜的条件。

实验室的温度会被精确控制在37℃±0.1℃。因为人体子宫内的温度恒定在37℃左右,温度过低会导致胚胎分化速度减慢甚至停滞,温度过高则会破坏胚胎内的蛋白质结构,导致细胞死亡或染色体异常。气体浓度也是关键因素之一,实验室会将二氧化碳(CO₂)浓度控制在5%±0.1%,氧气浓度控制在5% ±0.5% ,模拟子宫内含有较高二氧化碳和较低氧气的“低氧环境”,这样能减少胚胎的氧化应激损伤,促进胚胎正常发育。CO₂还能维持培养基的pH值稳定,子宫内pH值约为7.2 - 7.4。如果CO₂浓度过低,培养基pH值会升高(变碱),导致胚胎细胞代谢紊乱;如果CO₂浓度过高,培养基pH值会降低(变酸),同样会影响胚胎发育。而低氧环境能减少胚胎内活性氧的产生,降低DNA氧化损伤的风险,进而提升胚胎的质量。培养基则为胚胎发育提供葡萄糖、氨基酸、维生素、矿物质等营养物质和生长因子。
在胚胎培养过程中,实验室工作人员会密切监测胚胎的发育情况,通过观察胚胎的形态、细胞分裂速度、碎片程度等指标,筛选出优质胚胎。
4、胚胎移植与后续监测

胚胎移植前,HRC专家会对女性的子宫进行评估,确保子宫内膜厚度适宜、血流丰富,为胚胎着床创造良好的条件。胚胎移植过程通常在超声引导下进行,HRC专家会将装有胚胎的移植管通过阴道缓缓进入子宫,然后将胚胎准确地放置在子宫腔内合适的位置上。
上一篇 > 精子碎片率高,美国试管婴儿养囊还有希望吗?
下一篇 > 哪些子宫因素会影响试管胚胎着床?